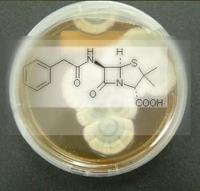
Топ-8 важливих випадкових відкриттів

Статистика

Онлайн всього: 1 Гостей: 1 Користувачів: 0
|
У категорії матеріалів: 10
Показано матеріалів: 1-10 |
|
Сортувати по:
Даті ·
Назві ·
Рейтингу ·
Коментарям ·
Переглядам
|
Топ-10 непотрібних органів

Чарльз Дарвін у своїй праці «Походження видів» (1859 р.) доводив теорію еволюції, спираючись на наявність атавізмів у різних видів. Ці непотрібні органи свідчили про зв’язок нащадків з предками. Існування спільних для ссавців атавізмів у вигляді зябер на етапі ембріонального розвитку свідчить про походження від одного предка.
|
|
Десять найпоширеніших хибних суджень в науці

Часто ми опиняємося під владою псевдонаукових помилок, через які разюче викривлюється картина оточуючого нас світу. Пропонуємо переконається у правильності ваших знань і переконань.
|
|
Топ-10 передбачень, які не здійснились

Автори фантастичних романів і режисери пригодницьких фільмів минулих століть пророкували нам безліч різних і неймовірних футуристичних змін.
Сьогодні ми усі повинні б ходити в універсальних комбінезонах і їздити на літаючих машинах або, може, жити в підводних державах. Але, на щастя, чи ні ці та декілька інших передбачень так і не здійснились, і видання TIME пропонує свій рейтинг 10 футуристичних прогнозів, обіцяних нам, але тих, які так і не втілилися в життя.
|
|
10 найновіших біотехнологій для здоров’я людини

Учені все ближче і ближче підходять до створення штучної людини. Принаймні, сьогодні ми вже можемо замінювати або відтворювати переважну більшість органів. Про найновіші біотехнології, котрі зовсім скоро служитимуть людям, розповідає портал livescience.com.
|
|
Топ-8 важливих випадкових відкриттів
Терпіння, наполегливість і відданість справі завжди вважалися великими чеснотами. Натомість у провалах і невдачах ніхто не бачить нічого хорошого. А тим часом світлий бік у поганого все-таки є. Доказом тому може слугувати хоча б список восьми важливих відкриттів, зроблених випадково – «завдяки» чиїмось лінощам, неохайності, незграбності й просто дурості.
|
|
9 вражаючих фото космосу

Космос завжди вражає. На фотографії Всесвіту можна дивитися знову і знову, кожного разу дивуючись і віднаходячи щось нове. Автори видання Scienceray сформували добірку найбільш вражаючих фотографій космічних тіл. На цих фото краса Всесвіту розкривається в усій її величі.
|
|
Шість наукових загадок, яким нема пояснення

Журнал New Scientist зробив добірку фактів, пояснити які вчені не в змозі. Лише деякі з них мають «земне походження», в основному ж належать до космічних феноменів. Найцікавіші з них представляє newsru.com.
|
|
12 цікавих фраз, які були спростовані часом

Завжди цікаво читати, що думали люди далекого і не дуже минулого про наш час, і порівнювати те, що передбачали або намагалися передбачити вчені, з поточною ситуацією. Наука змінюється щороку, включаючи загальну і прикладну науку, і завдяки цьому складно передбачити, що буде через рік, а не через десятиліття. Тим не менш, багато вчених намагаються робити прогнози, які суперечать реальності сьогоднішнього дня.
|
|
Цікаві факти про сміх

Дарвін відводив сміху важливу роль в еволюційному розвитку. Він вважав, що сміх допомагає у відновленні психічної стабільності. Фрейд вважав, що сміх допомагає справлятися з несприятливими думками.
|
|
Топ-10 антинобелівських лауреатів усіх часів

Багато наукових досліджень так ніколи й не переходять на службу людству. Чимало «найновіших розробок» є кальками забутих відкриттів. І лише невелика кількість наукових праць здобувають славу в професійних колах.
Поряд із цим існує ще одна категорія робіт, які можна класифікувати як сумнівні. Щороку організація Annals of Improbable Research висвітлює «здобутки» саме цієї категорії наукових проривів і нагороджує «найкращих» Антинобелівською премією.
|
|
|

